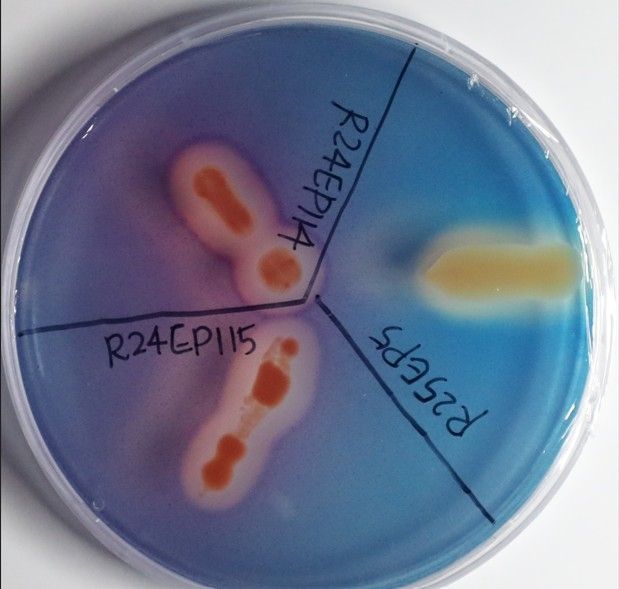
미생물 생성 장면

(목포=연합뉴스) 조근영 기자 = 국립호남권생물자원관(전남 목포시)은 국내 섬 지역에 자라는 염생식물에서 식물 생장을 돕는 미생물 46종을 새롭게 찾아냈다고 17일 밝혔다.
염생식물은 갯벌 지역을 대표하는 탄소고정 생물이자 식품·의약품 등 다양한 산업 분야에서 활용이 가능한 중요한 생물자원이다.
특히 염생식물과 공생하는 미생물은 식물 호르몬 생성, 질소고정, 병원균 저항성 증가 등의 기능을 수행하며 식물 생장에 도움을 주는 것으로 알려졌다.
생물자원관 연구진은 작년부터 목포시 고하도 갯벌에 서식하는 염생식물 '해홍나물'을 대상으로 공생미생물의 다양성과 특성을 조사해 왔다.
연구진은 확보된 세균 117종을 분석해 옥신 생성 등 식물 생장을 촉진하는 기능을 확인했으며, 그중 46종은 지금까지 관련 활성이 알려지지 않았던 미생물이라고 밝혔다.
연구진은 공생미생물의 분류학적 연구를 위해 유전체 분석과 시기별 다양성 변화 연구도 진행 중이다.
확보된 미생물자원은 호남권생물자원관 섬생물소재은행(BOBIC)을 통해 무료로 분양받을 수 있다.
호남권생물자원관 송재호 선임연구원은 "도서·연안의 소중한 생물자원인 염생식물과 공생미생물 연구는 갯벌 보전과 유용 생물소재 개발 등 미래 생물자원 활용의 중요한 기반이 될 것"이라고 말했다.
chogy@yna.co.kr
Copyright ⓒ 연합뉴스 무단 전재 및 재배포 금지